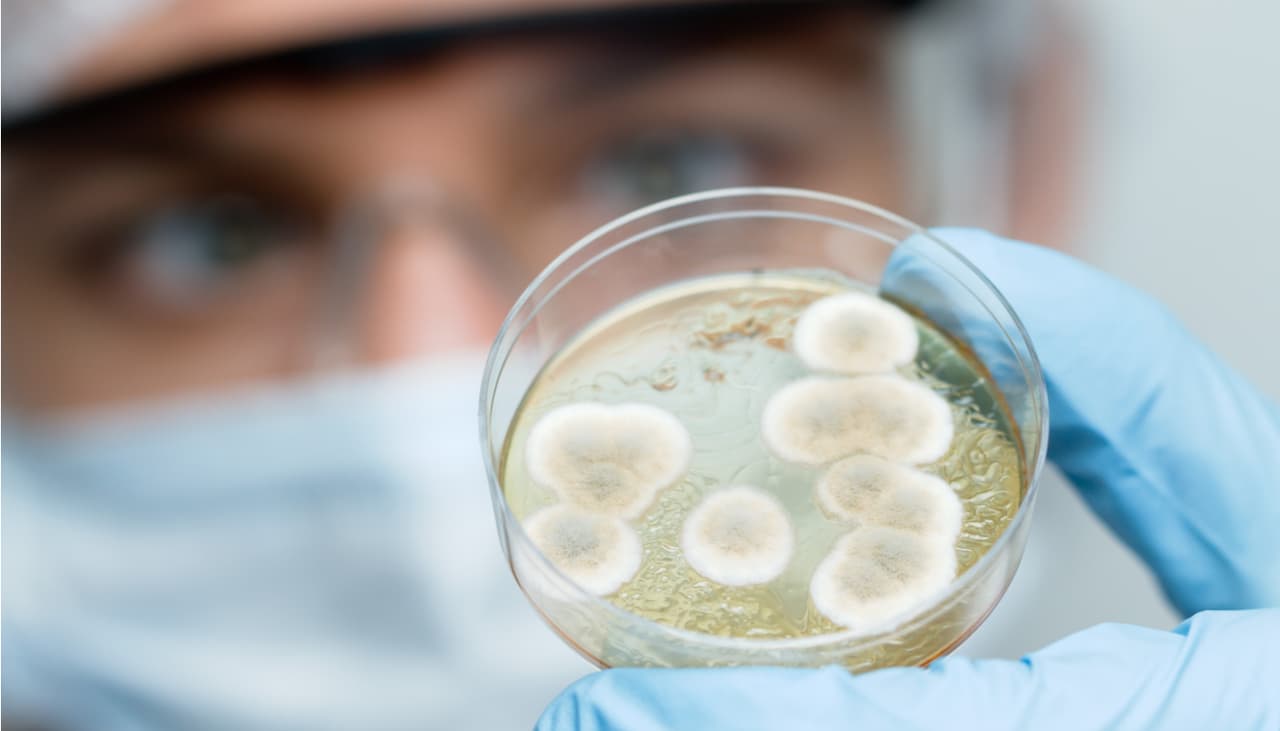
El eslabón perdido de las bacterias podría dar pistas sobre el origen de la vida en la Tierra

Investigaciones Cientificas
Investigaciones Cientificas: Últimas noticias, videos y fotos de Investigaciones Cientificas
Un grupo de peces podría salir del agua y empezar a caminar en cualquier momento, ¿los conoces?
Una familia de peces asiáticos podría salir del agua y caminar. Es un rasgo evolutivo que la ciencia no había detectado y que podría ayudar a descubrir cómo salieron el agua los primeros organismos terrestres.
LO MÁS RECIENTE

Tendremos internet imposible de hackear, un grupo de científicos explica la idea
El internet del futuro no solo podría ser muy veloz, también podría ser totalmente seguro e imposible de hackear gracias a la tecnología cuántica.

Eva no fue la mujer que dio origen a todas las demás personas, la ciencia tiene una respuesta
¿Todos los humanos provenimos de un ancestro en común que habitó el planeta hace miles de años? Una teoría genética podría indicar que es cierto gracias a los registros de ADN.

Los bebés nacidos en octubre tienen 6 habilidades superiores, según la ciencia
Entre el viento otoñal, los hermosos atardeceres y las hojas secas, octubre luce como un mes maravilloso para que nazca tu pequeñito.

Los agujeros negros no sólo destruyen planetas, también pueden crearlos
Un grupo de astrónomos japoneses propuso la idea de un nuevo tipo de planeta que se podría formar alrededor de un agujero negro masivo y ya le pusieron nombre.

Nunca es tarde para dejar de fumar: tus pulmones pueden recuperarse, según la ciencia
Los pulmones dañados tienen esperanza de recuperarse incluso después de fumar por décadas gracias a la magia del organismo.
El eslabón perdido de las bacterias podría dar pistas sobre el origen de la vida en la Tierra
Científicos japoneses cultivaron una bacteria durante 12 años para estudiar su linaje genético y los resultados podrían dar pistas sobre la evolución de la vida en la Tierra.














